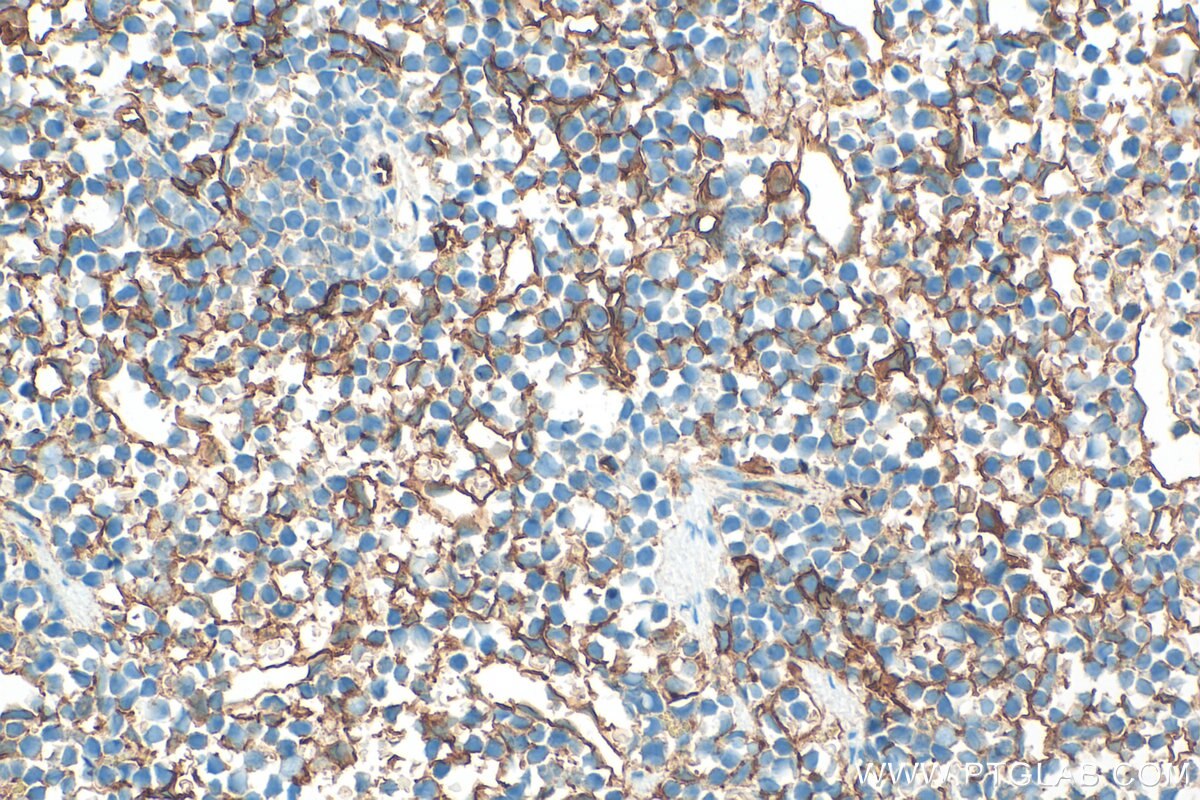
Immunohistochemical analysis of paraffin-embedded mouse spleen tissue slide using 32731-1-AP (CD36 antibody) at dilution of 1:2000 (under 40x lens). Heat mediated antigen retrieval with Tris-EDTA buffer (pH 9.0). Immunohistochemistry (IHC) staining of mouse spleen tissue using CD36 Polyclonal antibody (32731-1-AP)

Tested Applications
| Positive WB detected in | mouse spleen tissue, rat spleen tissue |
| Positive IHC detected in | mouse spleen tissue, mouse liver tissue Note: suggested antigen retrieval with TE buffer pH 9.0; (*) Alternatively, antigen retrieval may be performed with citrate buffer pH 6.0 |
Recommended dilution
| Application | Dilution |
|---|---|
| Western Blot (WB) | WB : 1:1000-1:6000 |
| Immunohistochemistry (IHC) | IHC : 1:1000-1:4000 |
| It is recommended that this reagent should be titrated in each testing system to obtain optimal results. | |
| Sample-dependent, Check data in validation data gallery. | |
Published Applications
| WB | See 1 publications below |
| CoIP | See 1 publications below |
Product Information
32731-1-AP targets CD36 in WB, IHC, CoIP, ELISA applications and shows reactivity with mouse, rat samples.
| Tested Reactivity | mouse, rat |
| Cited Reactivity | mouse |
| Host / Isotype | Rabbit / IgG |
| Class | Polyclonal |
| Type | Antibody |
| Immunogen |
CatNo: Eg3464 Product name: Recombinant Mouse CD36 protein (rFc Tag) Source: mammalian cells-derived, pHZ-KIsec-C-rFc Tag: C-rFc Domain: 30-439 aa of NM_007643.4 Sequence: GDMLIEKTIKREVVLEEGTTAFKNWVKTGTTVYRQFWIFDVQNPDDVAKNSSKIKVKQRGPYTYRVRYLAKENITQDPEDHTVSFVQPNGAIFEPSLSVGTEDDNFTVLNLAVAAAPHIYQNSFVQVVLNSLIKKSKSSMFQTRSLKELLWGYKDPFLSLVPYPISTTVGVFYPYNDTVDGVYKVFNGKDNISKVAIIESYKGKRNLSYWPSYCDMINGTDAASFPPFVEKSRTLRFFSSDICRSIYAVFGSEIDLKGIPVYRFVLPANAFASPLQNPDNHCFCTEKVISNNCTSYGVLDIGKCKEGKPVYISLPHFLHASPDVSEPIEGLHPNEDEHRTYLDVEPITGFTLQFAKRLQVNILVKPARKIEALKNLKRPYIVPILWLNETGTIGDEKAEMFKTQVTGKIK Predict reactive species |
| Full Name | CD36 antigen |
| Calculated Molecular Weight | 53 kDa |
| Observed Molecular Weight | 80-85 kDa |
| GenBank Accession Number | NM_007643.4 |
| Gene Symbol | Cd36 |
| Gene ID (NCBI) | 12491 |
| Conjugate | Unconjugated |
| Form | Liquid |
| Purification Method | Antigen affinity Purification |
| UNIPROT ID | Q08857 |
| Storage Buffer | PBS with 0.02% sodium azide and 50% glycerol, pH 7.3. |
| Storage Conditions | Store at -20°C. Stable for one year after shipment. Aliquoting is unnecessary for -20oC storage. 20ul sizes contain 0.1% BSA. |
Background Information
CD36, also named as GP3B and GP4, is a membrane glycoprotein present on platelets, monocytes, erythroid precursors, endothelial cells, and several tumor cell lines. CD36 binds to collagen, thrombospondin, anionic phospholipids, long chain fatty acids and may function in the transport and/or as a regulator of fatty acid transport and oxidized LDL. CD36 may function as a cell adhesion molecule. It mediates cytoadherence of Plasmodium falciparum parasitized erythrocytes. Mutation of CD36 will cause platelet glycoprotein IV deficiency which known as CD36 deficiency. Genetic variations in CD36 are associated with susceptibility to coronary heart disease type 7 (CHDS7).
Protocols
| Product Specific Protocols | |
|---|---|
| IHC protocol for CD36 antibody 32731-1-AP | Download protocol |
| WB protocol for CD36 antibody 32731-1-AP | Download protocol |
| Standard Protocols | |
|---|---|
| Click here to view our Standard Protocols |
Publications
| Species | Application | Title |
|---|---|---|
Food Funct Conjugated linoleic acid (CLA) reduces intestinal fatty acid uptake and chylomicron formation in HFD-fed mice associated with the inhibition of DHHC7-mediated CD36 palmitoylation and the downstream ERK pathway. |